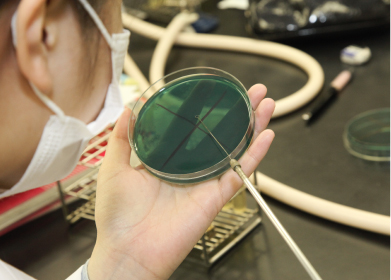

本学2年次の学内実習では、検査部門ごとに実習部屋割りを行い、学生が少人数のグループで各実習室を一定期間づつ回っていく「ローテーション実習」を実施しています。一定期間集中的に各検査部門の実習を行うユニークな方法をとっています。

実際の医療現場で実習を行う臨地実習は、学内で学んだ知識と技術を確かめると同時に、学校では学ぶことのできないより深い知識や現場の雰囲気、他職種との協力関係などを肌で感じ、医療人としての自覚をより強いものにします。また社会人としての振る舞いやコミュニケーションの大切さも実感できるでしょう。本校の卒業生は実習施設に必ずいますので、先輩からのきめ細かい指導を受けることができます。